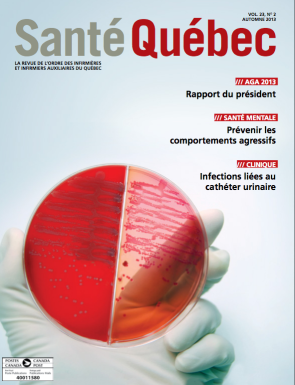
Automne2013

Revue Santé Québec

21 avril 2015
Printemps 2015

21 janvier 2015
Hiver 2015

15 septembre 2014
Automne 2014

22 avril 2014
Printemps 2014

13 janvier 2014
Hiver 2014
16 septembre 2013
Automne 2013

2 mai 2013
Printemps 2013

9 janvier 2013
Hiver 2013

13 septembre 2012
Automne 2012

2 mai 2012
Printemps 2012

13 janvier 2012
Hiver 2012

12 septembre 2011
Automne 2011

17 mai 2011
Hiver 2011

